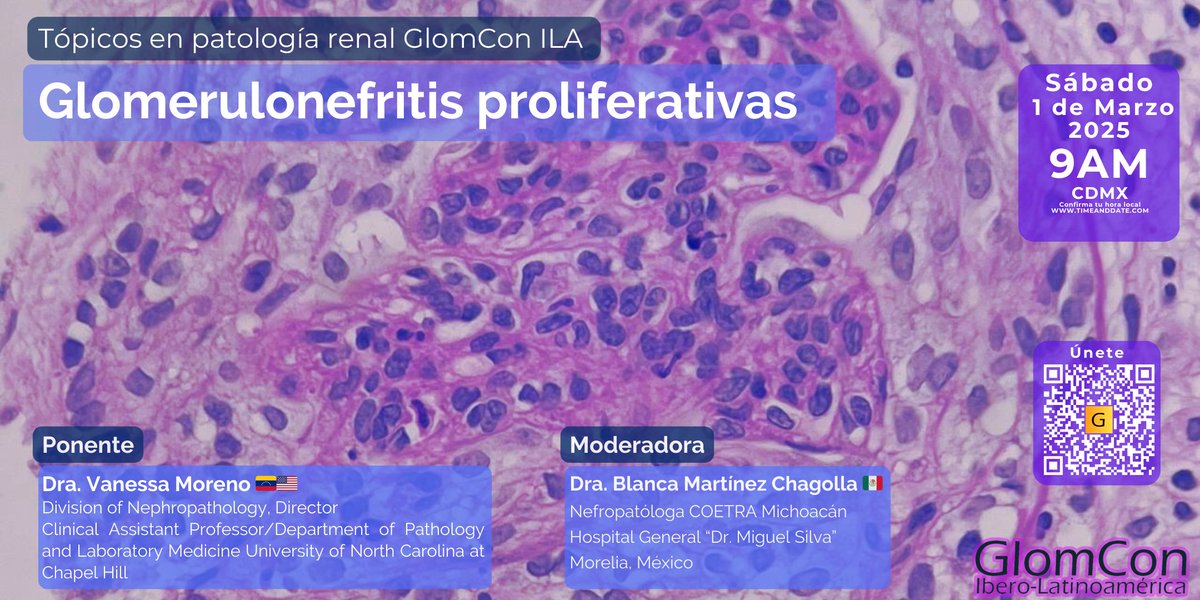
No te pierdas este sábado el seminario: 

☞ Glomerulonefritis proliferativas 🔬💯

🗓️ 1/Marzo/25
🕘 9 am CDMX
🧑🏻‍⚕️ Dra. Vanessa Moreno 🇻🇪🇺🇸

Zoom ID: 863 6358 3637
Pass: 343 190

#GlomConILA #GlomConAmor #MeGusta

Dr Alberto Ramirez
@albertorg_nefro
Internal Medicine and Nephrologist
ID: 1388989931704438786
02-05-2021 22:53:13
153 Tweet
165 Followers
579 Following














Los invitamos a leer una de las más recientes revisiones en #GlomConMagazine sobre Inmunosupresión en Nefropatía Membranosa 🧑⚕️: Jorge Gaytan Arocha Alejandro Garcia-Rivera 🇲🇽 🔗: ila.glomcon.org/inmunosupresio… #GlomConILA